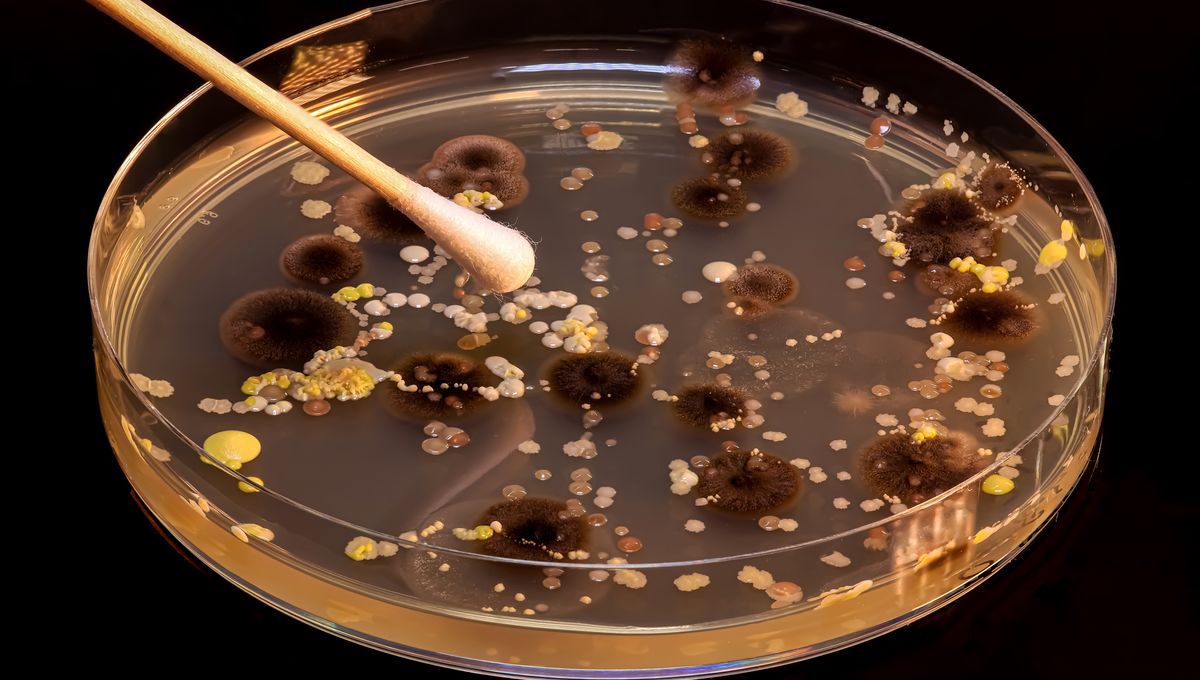

IFLScience
shared a link post in group #IFLScience

www.iflscience.com
Bye Bye Superbugs? New Antibiotic Is Virtually Resistance-Proof
Its two-pronged attack is almost impossible for bacteria to withstand.

IFLScience

shared a link post in group #IFLScience
www.iflscience.com
Bye Bye Superbugs? New Antibiotic Is Virtually Resistance-Proof
Its two-pronged attack is almost impossible for bacteria to withstand.
Comment here to discuss with all recipients or tap a user's profile image to discuss privately.
<div data-postid="roympvb" [...] </div>